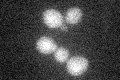
YIR038C

View description
ER associated glutathione S-transferase capable of homodimerization; expression induced during the diauxic shift and throughout stationary phase; functional overlap with Gtt2p, Grx1p, and Grx2p
Localization:
Intensity:
Fold change:
Significance:
-
C’ GFP library in SD
cytosol23.67 -
N' NOP1pr-GFP in SD

cell periphery,ER330.397 -
N' TEF2pr-mCherry in SD

cell periphery,ER514.314 -
N' NATIVEpr-GFP in SD

cell periphery,ER49.0622 -
N' TEF2pr-VC and Cyto-VN in SD

ER60.8483 -
C’ GFP library in SD+DTT

cytosol33.331.4Yes -
C’ GFP library in SD+H2O2

cytosol19.40.81No -
C’ GFP library in Starvation Media

cytosol61.672.6Yes -
C’ GFP library on the background of Pup2-DaMP

cytosol -
C’ GFP library on the background of CCT mutant

cytosol32.37131.3669No
